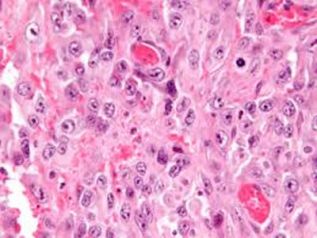
Investigadores de Mayo Clinic precisan causa y posible tratamiento para tipo raro de sarcoma

Medicina Digital
Diario Médico de México
Medicina Digital
Diario Médico de México
# Entérese
- Botones de vida, solución clave para la seguridad en el autismo
- Papel clave del baño en el bienestar cotidiano
- La IA revela el alcance oculto del marketing de refrescos y alcohol en las redes sociales, estudio
- ARTÍCULO :: Análisis bioético y metafísico del “aborto después de nacer”…
- Con 42 años impulsando la ciencia hecha en México, Roche abre la convocatoria del Premio Rosenkranz 2026
- La Industria Farmacéutica y de Dispositivos Médicos eje estratégico para Plan México
- Reconocer, tratar y prevenir las lesiones más comunes en deportistas
- Llega a México innovadora tecnología para tratar crisis epilépticas
Investigación (487)
Ciudad de México. En el ambiente existen contaminantes llamados emergentes; provienen de diferentes productos y cuando comenzaron a usarse nadie imaginó que se convertirían en un problema de contaminación. Es el caso de cientos de compuestos presentes en medicamentos o productos de uso personal, como champú, jabón o pasta de dientes.
Ciudad de México. Con el desarrollo de tecnologías como el microscopio electrónico o el láser, y de los sistemas de cómputo, los científicos han podido estudiar a profundidad las propiedades y los cambios de los sistemas nanométricos. “Ahora es más fácil poder crear sistemas a escalas nanométricas y también tener mayor control, porque cuando a un sistema a nanoescala se le cambia la forma puede responder de manera distinta, por ejemplo, a diferentes tipos de luz; lo mismo sucede si se le agrega o se le quita un átomo”, indicó la doctora Ana Cecilia Noguez Garrido, del Instituto de Física de la UNAM.
Ciudad de México. Estudioso desde hace más de cuatro décadas de los componentes y estructura del veneno de alacrán, el doctor Lourival Domingos Possani Postay recibió el Premio Nacional de Ciencias 2016 en el área de tecnología, innovación y diseño “por su contribución científica al estudio de la estructura y función de los péptidos y proteínas del veneno de los alacranes”. Con esto se convirtió en el primer mexicano en recibir en dos ocasiones el reconocimiento que otorga la Secretaría de Educación Pública, la primera vez fue en 1996 en el área de ciencias físico-matemáticas y naturales, esto es en ciencia básica.
Ciudad de México. Los avances científicos y la prevención en la salud han incrementado la esperanza de vida de la población mundial y de México. Las proyecciones del Consejo Nacional de la Población (Conapo) han pronosticado que para el año 2050, el 25% de los mexicanos será mayor a 65 años. Por ello, los estudios relacionados a la comprensión del proceso de envejecimiento ayudarán a prevenir el deterioro asociado al mismo, así como evitar o retardar algunas enfermedades asociadas a la edad como el cáncer, para así mejorar la calidad de vida de los adultos mayores.
Ciudad de México. Investigadores de Mayo Clinic, de la Escuela de Medicina de Harvard y del Instituto Tecnológico de Massachusetts actualmente desarrollan un biomaterial que conlleva el potencial de proteger a los pacientes con alto riesgo de sangrado en una cirugía.
Investigadores de Mayo Clinic precisan causa y posible tratamiento para tipo raro de sarcoma
Ciudad de México. Científicos del Centro para Medicina Personalizada de Mayo Clinic descubrieron una posible causa y un nuevo tratamiento esperanzador para los tumores miofibroblásticos inflamatorios, un raro tipo de cáncer del tejido blando que no responde a la radiación ni a la quimioterapia.
No hay muro que pueda contener la transferencia científica, diga lo que se diga: Enrique Cabrero
Ganadoras de becas L’ORÉAL-UNESCO-CONACYT-AMC 2016
Ciudad de México. Con un reconocimiento a su talento, creatividad y compromiso las cinco jóvenes científicas que este año se hicieron acreedoras a las Becas para las Mujeres en la Ciencia L´Oréal-Unesco-Conacyt-AMC 2016 recibieron hoy el importante incentivo para aplicarse en sus investigaciones, en una ceremonia celebrada en el Museo Nacional de Antropología, la cual estuvo presidida por los titulares de las instituciones participantes en este programa.
Ver notas por categoría
Lo + visto
Jul 05 2020 232796
Gasdem B, suplemento alimenticio creado con nanotecnología mexicana
Anuncio en blogs de categorías